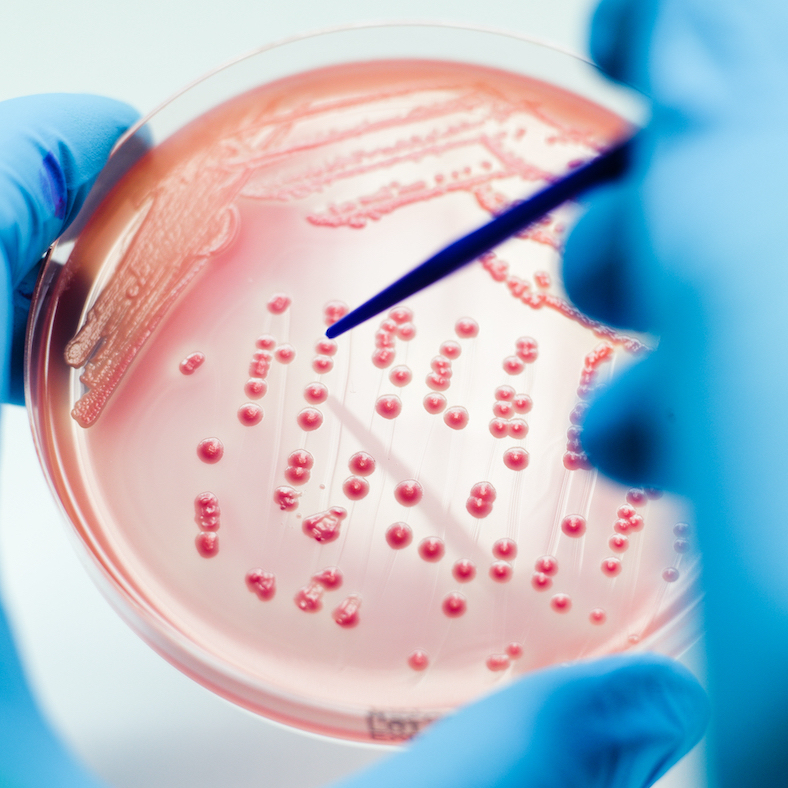
“Now's the time to get prepared for tomorrow’s health challenges”, says Dr 
@MoniqueEloit.

Joint work under #OneHealth must be strengthened to #BuildBackBetter after #COVID19 to face the threats of today &amp; tomorrow. #G7UK

MORE in #OneHealthforAll 👉 report2020oie.fr/en/animal-heal…

COST ASFstop
@cost_asfstop
#CostAction to stop African Swine Fever (#ASF) from spreading in Europe and protecting both the 🐷pig industry and wild boar 🐗populations
ID: 981498650911236096
https://www.asf-stop.com/ 04-04-2018 11:48:08
2,2K Tweet
580 Takipçi
535 Takip Edilen



#ASF update from the border area of Poland 🇵🇱 and Germany 🇩🇪. Total amount of cases is now 5,349 infected wild #boar with African #Swine Fever, of which 959 in Germany (situation this morning 9am). Read more in the PigProgress.net overview ⏩ bit.ly/3a64RKV








Excellent advice from APHA. Don't feed food scraps to pigs! National Farmers' Union National Trust English Heritage

#COST50years #successstories 🧑🔬Discover how #COSTAction AMiCI Consortium contributes to development of innovative germ-killing coatings technology for hospitals. Read the article on our dedicated "50 years" website here 👉bit.ly/3woEoBu



Research community, have your say! What are the gaps, barriers and priorities in the research and innovation of veterinary #vaccines globally? Share your views via the Biotechnology and Biological Sciences Research led Veterinary Vaccinology Landscape Survey - details here ➡️ ow.ly/r7oy50F9VqL UK Research and Innovation




Update on the #ASF situation in Haiti 🇭🇹 and the Dominican Republic 🇩🇴. Several infected #pigs were found in Haiti's capital Port-au-Prince. Meanwhile, the Dominican Republic can now test for African #Swine Fever itself. Read the story in PigProgress.net ⏩ bit.ly/3GyVW27



Following @ASFvacdivaworkshop on African Swine Fever mitigation and vaccine trials. Oral baits for wild boar? sucrose-and-cinnamon-truffle. I, too, would be tempted to eat COST ASFstop (getting social with) BOAR @SVAexpertmyndig



![Timothée Vergne (@timvergne) on Twitter photo 📄[New publication] Happy to share our systematic review on mechanistic models of African swine fever #ASF that has just been accepted in PVM. Well done @TheDrsHayes for this achievement!
sciencedirect.com/science/articl… 📄[New publication] Happy to share our systematic review on mechanistic models of African swine fever #ASF that has just been accepted in PVM. Well done @TheDrsHayes for this achievement!
sciencedirect.com/science/articl…](https://pbs.twimg.com/media/Eza-b-wVcAIHOmF.jpg)